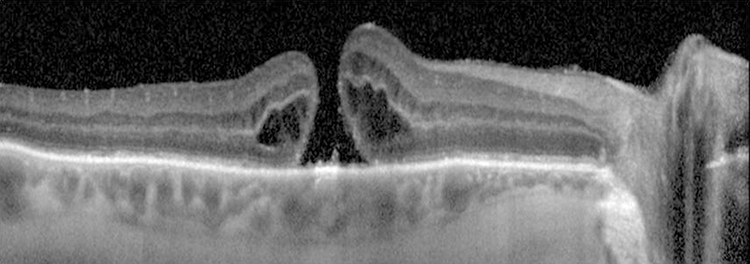
Rapuano9781975243722-ch011_f045.jpg

Variable decreased vision (typically around 20/200 level for a full-thickness hole, better for a partial-thickness hole), metamorphopsia, or central scotoma. Three times more likely in women; usually occurs in sixth to eighth decade. Ten percent bilateral.
(See Figures 11.25.1 and 11.25.2.)
Figure 11.25.1: Macular hole.

Figure 11.25.2: Optical coherence tomography of macular hole.

Critical
A full-thickness macular hole appears as a round, red spot in the center of the macula, usually from one-third to two-thirds of a disc diameter in size; may be surrounded by a gray halo/cuff of SRF. VMT demonstrates loss of the normal foveolar depression and often a yellow spot or ring in the center of the macula.
Other
Small, yellow precipitates deep to the retina in the hole or surrounding retina; retinal cysts at the margin of the hole or a small operculum above the hole, anterior to the retina (Gass stage 3 or 4); or both.
Gass Classification of Macular Hole
Stage 1: An impending (non–full-thickness) hole, yellow spot, or ring in fovea.
Stage 2: Small full-thickness hole (<400 µm diameter), rim of elevated retina, no PVD.
Stage 3: Full-thickness hole (≥400 µm diameter), rim of elevated retina, with or without localized operculum over hole, no PVD.
Stage 4: Full-thickness hole (≥400 µm diameter), with complete PVD.
|
 NOTE NOTEA new classification system using OCT has been developed. It is based on size of the full-thickness hole, presence of VMT, and underlying etiology (e.g., primary VMT vs. secondary trauma). |
May be difficult to distinguish a macular hole from a pseudohole (no loss of foveal tissue) or a lamellar macular hole (partial thickness).
Macular pucker with a pseudohole: An ERM (surface-wrinkling) on the surface of the retina may simulate a macular hole. See 11.26, Epiretinal Membrane (Macular Pucker, Surface-Wrinkling Retinopathy, Cellophane Maculopathy). Look for a sheen from ILM changes or ERM.
Lamellar hole: Not as red as a full-thickness hole, and a surrounding gray halo is usually not present.
Intraretinal cysts (e.g., chronic CME with prominent central cyst).
Solar retinopathy: Small, round, red or yellow lesion at the center of the fovea, with surrounding fine gray pigment in a sun gazer or eclipse watcher. See 11.35, Solar and Photic Retinopathy.
May be caused by vitreous or ERM traction on the macula, trauma, or CME. In early stages of vitreomacular adhesion (VMA)/VMT, the vitreous cortex is attached to the fovea but detached from the perifoveal region, exerting anteroposterior traction on the fovea. Increased tractional forces can allow for eventual progression to full-thickness macular hole.